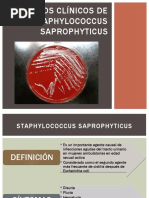
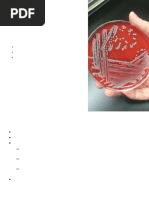

0% encontró este documento útil (0 votos)
175 vistas7 páginasTratamiento de Staphylococcus epidermidis
Este documento presenta los resultados del análisis bacteriológico de una muestra de orina de una paciente de 35 años que fue sometida a cirugía por un absceso pélvico. La prueba identificó Staphylococcus epidermidis como el agente causante de la presunta infección de vías urinarias. El tratamiento recomendado fue clindamicina y azitromicina.
Cargado por
ALITZA ANTUANETE CHAGUA OBREGONDerechos de autor
© © All Rights Reserved
Nos tomamos en serio los derechos de los contenidos. Si sospechas que se trata de tu contenido, reclámalo aquí.
Formatos disponibles
Descarga como PDF, TXT o lee en línea desde Scribd
0% encontró este documento útil (0 votos)
175 vistas7 páginasTratamiento de Staphylococcus epidermidis
Este documento presenta los resultados del análisis bacteriológico de una muestra de orina de una paciente de 35 años que fue sometida a cirugía por un absceso pélvico. La prueba identificó Staphylococcus epidermidis como el agente causante de la presunta infección de vías urinarias. El tratamiento recomendado fue clindamicina y azitromicina.
Cargado por
ALITZA ANTUANETE CHAGUA OBREGONDerechos de autor
© © All Rights Reserved
Nos tomamos en serio los derechos de los contenidos. Si sospechas que se trata de tu contenido, reclámalo aquí.
Formatos disponibles
Descarga como PDF, TXT o lee en línea desde Scribd